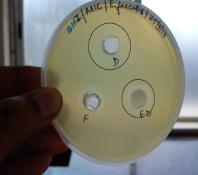
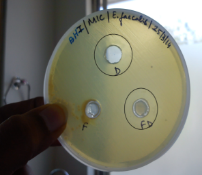
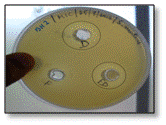
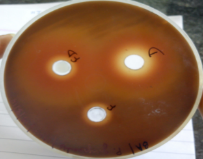
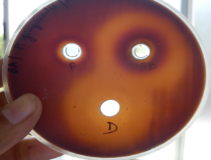

Department of Pharmaceutics, KLEU’S College of Pharmacy, JNMC Campus, Nehru Nagar,Belgaum 590010, India.1
Email: joshi.mugdha@rocketmail.com
Received: 21 May 2014 Revised and Accepted: 02 Jul 2014
ABSTRACT
Objective: The objective of the present work was to formulate thermoreversible sol gel of cefuroxime axetil using Pluronic F127 and Pluronic F108. Cefuroxime axetil is a broad spectrum, second generation antibiotic used to treat various infectious diseases. Thermoreversible sol gels are shear thinning systems which show temperature dependent gelation. Once injected, the gel covers every nook and corner of the periodontal pocket thus filling it completely and is retained in the pocket.
Methods: Gels were prepared by cold technique varying the polymer concentration.
Results: The FTIR results revealed the compatibility between the drug and polymers. Drug content prior and after gelation was found to be in the range 98.8-99.8% and 98.2-99.6% respectively. The pH was in range of 6.9-7.1. The viscosity of the formulations at 250±10C and 370±10C was in the range of 530-705 cps and 1000-2100 cps respectively. The results obtained were in agreement with the phase transition. All the formulations were syringeable through 20 gauge needle. The in vitro drug release revealed a sustained profile over a period of 7 days and was found to be highest for formulation F3 i.e. 97.83%. The in vitro antimicrobial study showed promising activity of F3 against clinical isolates of P.gingivalis, E.faecalis and S.mutans. Short term stability study indicated that 40±10C is appropriate storage condition for the formulations.
Conclusion: The results indicated that the formulated sol gel can definitely be used for once a week treatment for periodontitis
Keywords: Cefuroxime axetil, Pluronic F127, Thermoreversible sol gel, Cold technique.
INTRODUCTION
It is estimated that approximately 10-30% of the population suffers from periodontal diseases with pathological periodontal pockets [1]. Periodontitis is defined as an inflammatory disease of the supporting tissues of the teeth caused by specific microorganisms or groups of specific microorganisms resulting in progressive destruction of the periodontal ligament and alveolar bone with pocket formation, recession or both[2]. It can be categorised in various forms viz. aggressive periodontitis, chronic periodontitis, periodontitis as a manifestation of systemic disease and so forth. The progression of this disease cannot be blamed on the microbial attack alone. The patient’s immune system is also believed to play a part. Severe Periodontitis can result in loosening of teeth, occasional pain and discomfort, impaired mastication, and eventual tooth loss[3, 4, 5]. Disease occurs at individual periodontal sites and leaves an historical record of the damage to the periodontium in the form of periodontal attachment or bone loss [6].
Mechanical debridement and oral hygiene have been sought traditionally to treat the disease. But the mechanical treatment fails owing to the fact that the dental pathogens inhabit the affected gum line and flourish. Hence supplementation of the existing therapy with antibiotics was opted for. The accepted way of administering antibiotics then for treatment was via oral route. But the knowledge of the limitations of this route paved entry for investigation of other alternative modes of administering the antibiotics. Site specific drug delivery was looked in to as it overcame the limitations of the oral systemic delivery and offered more benefits. The causative organism being localized justifies the use of site specific drug delivery systems. Another added benefit is that the pocket formed can be harnessed to house the drug delivery device. Studies have suggested that the critical period of exposure of the pocket to an antimicrobial agent is 7-10 days[7]. This can be easily achieved using a controlled release local drug delivery system.
Various site specific drug delivery systems viz. fibers, strips, films, implants etc. have been developed for the treatment of periodontitis. But the limitation of all the above formulations is that they cannot cover up the entire pocket. This gives opportunistic pathogens a chance to inhabit the pit. The thermoreversible sol gel/ hydrogel systems can overcome the aforementioned limitation giving site specific drug delivery an upper hand over systemic delivery. Thermoreversible sol gels are shear thinning systems which show temperature dependent gelation. Poloxamers are usually employed to form the gel system. These polymers show temperature dependent sol to gel phase transition. The aqueous solutions of these polymers are liquid at room temperature but gel at body temperature. Once injected, the gel covers every nook and corner of the periodontal pocket thus filling it completely. Since it gels at body temperature it is retained in the pocket. The gel system sustains the drug delivery thus reducing the frequency of administration. Administration of a gel formulation is convenient from the periodontist point of view too. Cefuroxime axetil is a semisynthetic, broad spectrum, 2nd generation Cephalosporin antibiotic. It is commercially available in the form of tablets and capsules. It belongs to peptidoglycan synthesis inhibitor pharmacological class. In the present study a successful attempt was made to formulate a thermosensitive sol gel with Pluronic F127 and Pluronic F108 using cefuroxime axetil for once a week treatment of periodontitis.
MATERIALS AND METHODS
Materials
Cefuroxime axetil was purchased from Kwality Pharmaceuticals Pvt. Ltd, Amritsar. Pluronic F127 and Pluronic F108 were obtained from Sigma Aldrich, USA. The other reagents used were of analytical grade.
Method
Compatibility study
FTIR study was carried out to identify the drug sample and establish drug polymer compatibility.
Preparation of formulations
The poloxamer gel was prepared by cold technique as described by GraciaSadgrado et al. Accurately weighed amount of the polymers were dissolved in cold (40C) distilled water and stirred on magnetics stirrer for a period of 30 minutes at 200-300rpm. Low speed was employed to ensure the absence of froth formation. Then the container was sealed with aluminum foil and refrigerated overnight at 40-50 C to get a clear solution, since poloxamers are soluble in water at low temperatures. To the clear solution obtained, known amount was drug was dispersed by stirring at 300 rpm for 45 minutes. After the drug is dispersed, preservative is added and the prepared gel is stored at 40 C. Concentration of Pluronic F127 was first optimized from 16 – 22%w/v.
Later the formulations were prepared keeping the concentration of Pluronic F127 constant and varying the concentration of Pluronic F108 from 2 - 10%w/v.
Table 1: It showscomposition of formulations F1-F5
| Formulation | Pluronic F127(%w/v) | Pluronic F108(%w/v) | Cefuroxime axetil(%w/v) | Benzalkonium chloride(%w/v) | Distilled water(ml) |
| F1 | 18 | 2 | 1 | 0.05 | 100 |
| F2 | 18 | 4 | 1 | 0.05 | 100 |
| F3 | 18 | 6 | 1 | 0.05 | 100 |
| F4 | 18 | 8 | 1 | 0.05 | 100 |
| F5 | 18 | 10 | 1 | 0.05 | 100 |
Evaluation of the sol gel formulations
Drug content
1ml of formulation is transferred into 100ml volumetric flask containing 25ml mixture of 20:80 methanol: phosphate buffer pH 6.8. Shake flask vigorously to mix the contents. Make up the volume to 100ml with mixture of 20:80 methanol: phosphate buffer pH 6.8. Filter and dilute 1ml of the above solution to 10 ml mixture of 20:80 methanol: phosphate buffer pH 6.8.
Measure the absorbance at lambda max of 281nm. The drug content analysis was carried out before and after gelling to ascertain the drug content uniformity. Gel formulation equivalent to 1ml was weighed and the drug content was determined by the above mentioned method.
pH determination
The formulated gels are evaluated for pH using digital pH meter. The instrument is to be calibrated before each use with standard buffers.
Viscosity
The viscosity studies of all the formulations (F1 to F5) were carried out by using Brookfield digital viscometer (Brookfield DV II+, USA) with spindle number 21 at 50 rpm. Viscosity was measured at 25°C±1 and at 37±1°C using a thermo stated water jacket.
Syringeability
All prepared formulations were transferred into an identical 5 ml plastic syringe placed with 20 gauge needle to a constant volume. The solutions which were easily passed from syringe was termed as pass and difficult to pass were termed as fail.
Gelation Temperature
10 ml of the formulation was placed in a clean glass beaker. This beaker is then placed on a magnetics stirrer with heating element. The Formulation is stirred at minimum speed by gradually increasing the temperature. The temperature at which the magnetic bead stops rotating is taken as the gelation temperature.
Gel Strength
It is measured by method reported by Choi et al. 50g formulation is placed in 100ml graduated cylinder and gelled at 370 using thermostat. A 35g weight is placed on to gelled form and allowed to penetrate 5cm. Time required for penetration is noted and reported as gel strength.
Gelation time
It is the time taken by the formulation to gel completely. The procedure followed is same as that for gelation temperature. 10 ml of the formulation was placed in a clean glass beaker. This beaker is then placed on a magnetic stirrer with heating element. The Formulation is stirred at minimum speed by gradually increasing the temperature. The temperature at which the magnetic bead stops rotating is taken as the gelation time.
In vitro drug release study
In vitro drug release study was carried out using 6 stations Franz diffusion cell (PermeGear Inc. Hellertown, PA 18055, USA). The donor and the receptor compartments were separated by a dialysis membrane (Himedia Labs, Mumbai) having molecular weight cut off value of 12,000-14,000. The receptor compartment contained mixture of 20:80 methanol: phosphate buffer pH 6.8. 1ml of the formulation was placed in the donor compartment which was sealed form the top using an aluminium foil. The whole assembly was maintained at 37±10 C and under slow magnetic stirring. At regular intervals of 2, 4, 6, 8, 24, 48, 72, 96, 120, 144 and 168 hours, aliquots of 0.5 ml were withdrawn and the was replaced with same amount of mixture of 20:80 methanol: phosphate buffer pH 6.8to maintain the sink conditions. The amount of drug released was assayed spectrophotometrically (Shimadzu UV-1700, Japan) at wavelength of 281nm after suitable dilution.
In vitro antimicrobial studies
The in vitro antimicrobial studies of the optimized formulation were carried out on the clinical isolates of P.gingivalis, S.mutans and E.faecalis. The minimum inhibitory concentration (MIC) of drug was determined against all of the three microorganisms. Antibiotic susceptibility test of the optimized formulation against the aforementioned three organisms was done by measurement of zone of inhibition.
Minimum inhibitory concentration
Minimum Inhibitory Concentration (MIC) of the given drug was determined by Broth dilution method against bacterial culture. Brain Heart Infusion (BHI) media was used and 1% drug solution was prepared in Dimethylsulfoxide (DMSO). For S.mutans and E.faecalis BHI broth was used whereas for P.gingivalis the BHI was supplemented with hemin and Vit. K. Total 9 dilutions of the drug were done with media for MIC. In the initial tube only 200 µl of drug was added. For dilutions 200 µl of BHI broth was added into the next 9 tubes separately. In the 2nd tube 200 µl of drug was added which already contains 200 µl of BHI broth. This was considered as 10-1 dilution. From 10-1 diluted tube 200 µl was transferred to second tube to make 10-2 dilution. The serial dilution was repeated up to 10-8 dilution for each drug. From the maintained stock cultures of required organisms, 5 µl was taken and added into 2 ml of BHI (brain heart infusion) broth. In each serially diluted tube 200 µl of above culture suspension was added. The last tube contains only the media and culture suspension. The tubes were kept for incubation for 24 hrs at 370C in bacteriological incubator and observed for turbidity.
Measurement of zone of inhibition
The measurement of zone of inhibition was done by well plate method. For S.mutans and E.faecalis BHI broth was used whereas for P.gingivalis the BHI was supplemented with hemin and Vit. K. Optimized formulation F3 (FD), formulation without drug (F) and 1% drug solution in PEG 400 (D) was assessed for antimicrobial activity.
A drop of the culture was put on the plate and smeared over the plate surface with a swab or L- shaped rod. Two wells were made in one plate and 100 µl of formulation without drug (Placebo) was added in 1 well and 100 µl of formulation with drug was added into another well. In second plate one well was made and 100 µl of drug solution was added to it. Both the plates were incubated for 5 days at 370C in bacteriological incubator and the zones were measured at 24, 48, 72, 96 and 120 hrs. In case of P.gingivalis the plates were incubated in anaerobic jars.
Kinetic release study
The in-vitro release data of optimized formulation were kinetically analyzed for establishing kinetic of drug release of drug. Model fitting was done using Microsoft Excel 2013. Zero order, First order, Higuchi and Korsemeyerpeppas models were tested. The best fit model was selected on basis of relatively high co-relation coefficient value and least F value.
Short term stability studies
The optimized formulation was chosen to perform short term stabilitystudies. Samples were stored in glass vials for 2 months at 4 ºC in freeze and at room temperature. After 30 and 60 days, samples were visually observed for any sedimentation. The formulation was evaluated for pH, drug content, gelation temperature, viscosity and syringeability every one month interval
RESULTS AND DISCUSSION
Compatibility studies
FT-IR spectroscopy was carried out to study the compatibility of pure drug cefuroxime axetil (CA) with the polymer Pluronic F127 (F127) and Pluronic F108 (F108) used in the formulation of sol gels. The pure cefuroxime axetil has characteristic IR peaks at 1670.35 cm-1 (C=O stretch), 1782.23 cm-1 (C=O cyclic) and 3446.79 cm-1 (N-H stretch) as depicted in Figure 6. The peaks for C=O (carbonyl) and C-H (non-aromatic) are found in the range of 1444.68 – 1502.55 cm-1 and 2812.21 – 2976.16 cm-1 respectively.
The IR spectra of the physical mixture of both exhibited all the characteristic peaks of drug as depicted in Figure 7 and Figure 8 for physical mixture of drug with Pluronic F127 and drug with Pluronic F108 respectively. Therefore, it shows compatibility of drug with the polymer.
Drug content
Amount of the drug present in the formulation is not to deviate beyond specified limits of the labeled amount. In the present study drug content was calculated before and after gelation. The reason for it being that the drug was suspended in the gel formulation. Owing to the water insolubility of the drug, it had to be suspended. Since it is known that poloxamers have surfactant property, the possibility of emulsifying the drug cannot be denied. The only concern was non uniformity in dosage on syringeability so drug content after gelation was calculated for. The results indicated that the drug content did not vary to a significant extent after gelation thus ensuring uniformity in dosage upon syringeability. All formulations were found to have drug content in the range of 98.87-99.45% before gelation and 98.34-99.68 after gelation representing homogenous drug distribution throughout gel as shown in table 2.
pH determination
The normal physiological pH of GCF ranges from 7.2 to 7.6 and a mouth saliva pH from 6.4 to 7.4. The pH of all gel formulation was found to be in a range of 6.9-7.0 which is between the physiological ranges of pH of mouth saliva as depicted in Table 4.
Viscosity
Any formulation suitable for application to the periodontal pocket should ideally have a low viscosity when applied and after administration should have a high viscosity in order to stay at the application site8. The increase in viscosity of the formulations was directly proportional to polymer concentration. Moreover the measurement of viscosity at 250C and 370C confirmed sol to gel phase transition at body temperature. The viscosity of all formulations at 250 ±10C was obtained in the range of 530 -710 cps while the viscosity values at 370 ±10C were obtained in the range of 1000 – 2015 cps as shown in table 3

Fig. 1: It shows FITR spectra of pure drug

Fig.2.It shows FTIR spectra of drug and PF127

Fig. 3: It shows FTIR spectra of drug and PF108
Table 2: It shows drug content of formulations F1-F5 before and after gelation
| Formulation | Drug content (before gelation) (%) | Drug content (after gelation) (%) |
| F1 | 99.45 ±0.374 | 98.95±0.559 |
| F2 | 98.87±0.509 | 98.27±0.482 |
| F3 | 99.85±0.616 | 99.68±0.349 |
| F4 | 98.95±0.432 | 98.34±0.548 |
| F5 | 99.37±0.547 | 99.08±0.379 |
Table 3: It shows viscosity of formulations F1-F5 at 250 ±10 C and 370±10 C
| Formulation | Viscosity at 250 ±10 c(cps)Spindle no:2150 rpm | Viscosity at 370±10 c(cps)Spindle no:2150 rpm |
| F1 | 538±0.509 | 1028±0.512 |
| F2 | 594±0.485 | 1215±0.457 |
| F3 | 620±0.398 | 1570±0.591 |
| F4 | 659±0.475 | 1889±0.558 |
| F5 | 705±0.498 | 2015±0.602 |
Syringeability
This evaluation parameter indicates the ease with which the formulation can be injected into the periodontal pocket. Syringeability is in turn dependent on the viscosity. Increase in viscosity of sol phase decreases syringeability of the formulation. The force required to expel out the contents of syringe increased with increase in polymer concentration but none formulation failed the test. The results of this test are depicted in table 4.
Gelation temperature
At low temperature a hydration layer surrounds poloxamer molecules in aqueous solutions. With increase in temperature the hydrophobic chains of the copolymer undergo desolvation due to breaking of hydrogen bonds previously formed between the solvent and these chains. This promotes hydrophobic interactions among the polyoxypropylene domains and leads to gel formation. It is reported that the formed gel is micellar in nature. Micelles occur in different shapes viz. spherical, cylindrical etc.
A stable liquid micellar phase at low temperature turns to cubic phase with increase in the temperature. Further increase in temperature leads to formation of hexagonal structure.
Gelation of PF-127 is thought to occur as a result of dehydration of the polymer leading to increased chain friction and entanglement, producing a hydrophobic association [9,10]. The gelation temperature of the formulations increased with increase in polymer concentration, reached a maximum and then decreased with further increase in the polymer concentration as shown in table 4. It may be attributed to the higher number and volume occupied by micelles at lower temperature. As the concentration of F127 and F108 increases, the gel structure becomes more closely packed with the arrangement in a lattice pattern.
Gel strength
The gel strength of the formulation at 370 C increased as the concentration of the polymers increased as shown in table 4. The mechanism of the increase gel strength might be related to hydrogen bonding between Pluronic and in the gel. It is observed that the thickening power of poloxamer in water increases as the molecular weight of hydrophobic molecule increases and as the ethylene oxide/propylene oxide ratio increases. The gel structure is thought to remain unaltered with temperature until an excessively high temperature causes the destruction of the gel structure. At higher temperatures, the gel undergoes dehydration, but excessive hydrogen bonding and closely packed micelles restrict the destruction of the gel structure [11,12].
Gelation time
This evaluation parameter measures the time taken by the formulation to gel at body temperature. It goes without saying that lesser the gelation time faster is the gelation. The gelation time is inversely proportional to the gelation temperature. Increase in gelation temperature decreases the gelation time. This parameter is important from the view point of avoiding the loss of formulation due to flush of gingival cervical fluid (GCF) in the mouth before the pocket is covered with periodontal pack. All the formulations showed decrease in gelation time with increase in gelation temperature as shown in Table 4.
Table 4: It shows pH, Gelation temperature, Gel strength, Gelation time and Syringeability of formulations F1-F5
| Formulation | pH(Mean±SD) | Gelation temperature (0c)(Mean±SD) | Gel strength(seconds)(Mean±SD) | Gelation time(seconds)(Mean±SD) | Syringeability |
| F1 | 6.9±0.25 | 30±0.42 | 90±4.115 | 40±4.13 | PASS |
| F2 | 7.0±0.21 | 32±0.51 | 98±4.203 | 49±4.25 | PASS |
| F3 | 7.0±0.12 | 36±0.45 | 105±4.342 | 57±4.34 | PASS |
| F4 | 7.0±0.15 | 38±0.59 | 114±4.588 | 79±4.59 | PASS |
| F5 | 6.9±0.18 | 30±0.53 | 122±4.853 | 45±4.83 | PASS |
In vitro drug release
In vitro drug release from the gel formulation in mixture of 20:80 methanol: phosphate buffer pH 6.8 was performed using six stations Franz diffusion cell. The profiles are biphasic, with an initial burst of drug release, followed by a phase of slower release as drug entrapped inside the hydrophobic core of the micelles. All the formulations showed sustained release over a period of seven days thus making it possible to be used as once a week treatment for periodontitis as shown in Figure 4. The values of drug released at the end of seven days ranged from 89 – 97%.The lower drug release of formulations F4 and F5 as compared to the rest may be attributed to the high polymer concentration in the former. With increase in the polymer concentration, the micelles formed are closely packed on gelation thus resisting the drug release to the external environment. Another reason that can be thought of is the entrapment of the drug into the hydrophobic core situated deeply inside the lattice formed. Of all the formulations, F3 showed the most sustained and higher release of 97.84% at the end of seven days.
These results indicated that the structure of the gel functioned as a barrier to drug release. Such enhanced resistance may be due to the increase in the size of micelles within the gel structure, which led to higher viscosity and sustained drug release. The in vitro drug release profile of the gel formulations is shown in Table 5.
Table 5: It shows In vitro drug release data of formulations F1-F5
| Time(hours) | Cumulative Drug Release (%) | ||||
| F1 | F2 | F3 | F4 | F5 | |
| 24 | 29.95 | 30.53 | 30.99 | 29.07 | 27.24 |
| 48 | 36.56 | 46.57 | 47.03 | 38.12 | 36.17 |
| 72 | 52.68 | 61.83 | 63.0 | 59.77 | 47.77 |
| 96 | 64.97 | 71.50 | 72.21 | 67.54 | 57.39 |
| 120 | 74.86 | 80.12 | 82.16 | 78.86 | 67.41 |
| 144 | 84.90 | 88.55 | 91.51 | 86.26 | 77.81 |
| 168 | 94.78 | 95.09 | 97.84 | 92.54 | 89.39 |
Table 6: It shows release kinetics data of formulation F1-F5
| Formulation | Zero Order(R2) | First Order(R2) | Higuichi(R2) | Korsmeyer peppas | |
| (R2) | n | ||||
| F1 | 0.969 | 0.912 | 0.997 | 0.973 | 0.528 |
| F2 | 0.935 | 0.960 | 0.995 | 0.991 | 0.529 |
| F3 | 0.941 | 0.908 | 0.994 | 0.991 | 0.546 |
| F4 | 0.961 | 0.846 | 0.980 | 0.980 | 0.527 |
| F5 | 0.951 | 0.975 | 0.987 | 0.974 | 0.519 |

Fig. 4: It shows comparative diffusion profile of formulations F1-F5
Kinetics of drug release
The release data were fitted to various kinetic models in order to calculate the release constant and regression coefficients (R2) as seen in Table 6. Among the models tested, the drug release profiles for formulations (F1 to F5) were best fitted with Higuchi Matrix model based on regression coefficients of 0.997, 0.995, 0.994, 0.980 and 0.987 respectively. The linearity of the plot indicated that the release process was diffusion-controlled as depicted in Figure 17 to Figure 19. Thus, the amount of drug released was dependant on the matrix drug load. The diffusion exponent (n) values for all formulations were more than 0.5, indicative of non-fickian mechanism of drug release.
Microbiological Studies
The antimicrobial studies were carried out on clinical isolates of P.gingivalis, S.mutans and E.faecalis isolated from plaque samples of patients suffering from periodontitis.
The studies were carried out in Dr. Prabhakar Kore’s Basic Science Research Centre, Belgaum. The study comprised of determining the MIC of cefuroxime axetil against the aforementioned microorganisms and testing of antimicrobial activity of the optimized formulation by measuring the zone of inhibition against the above microorganisms.
The minimum inhibitory concentration (MIC) was tested using 1% w/v solution of cefuroxime axetil in dimethylsulfoxide (DMSO). The results of the MIC are tabulated in table 7. From the results it is clear that the dose of the drug incorporated in the formulation is more than sufficient to arrest or inhibit the growth of the periodontal pathogens.
The antimicrobial susceptibility test of the optimized formulation indicates that the formulation shows promising antimicrobial activity in vitro. As seen from figure 5 and 6 the optimized formulation has static action against the growth of E.faecalis and S.mutans during the study period of five days respectively. Figure 7 shows the formulation to have bactericidal effect against P.gingivalis during the study period indicating its ability to kill the pathogen.
It is known that though being a secondary colonizer in periodontitis, the LPS (Lipopolysachharide) of P.gingivalis is responsible for the progression of the disease. From the results obtained it can be concluded that the formulation is effective in controlling the bacterial population in the disease.
Table 7: It shows MIC of cefuroxime axetil against clinical isolates of P.gingivalis, S.mutans and E.faecalis
| Organism | MIC (μg/ml) |
| E.faecalis | 6.25 ±0.052 |
| S.mutans | 12.5±0.0031 |
| P.gingivalis | 6.25 ±0.052 |

(A) 1Day (B)5Day
Fig. 5: It shows zone of inhibition of formulation F3 (FD), placebo formulation (F) and 1% drug solution in PEG 400 (D) against E.faecalis on Day 1 and Day 5 respectively.

(A) 1Day (B) 5Day
Fig. 6: It shows zone of inhibition of formulation F3 (FD), placebo formulation (F) and 1% drug solution in PEG 400 (D) against S.mutans on Day 1 and Day 5 respectively.

(A) Day 1 (B) Day 5
Fig. 7: It shows zone of inhibition of formulation F3 (FD), placebo formulation (F) and 1% drug solution in PEG 400 (D) against P.gingivalis on Day 1 and Day 5 respectively.
Short term stability studies
The physical appearance of the formulation F3 stored at room temperature changed slightly. The viscosity was found to increase when stored at room temperature but not in significant amount. The drug content of the formulation stored at 40 C showed slight variations but of that stored at room temperature varied significantly. This variation in the drug content can be attributed to the dehydration of gel formulation. Since drug is emulsified in the formulation, dehydration leads to settling of the drug particles. This produces anomalies in the drug content. The pH of formulations did not vary much over the period of 90 days at either temperature conditions. Same was true for gelation temperature. The results of the stability studies are as shown in table 8.
From the above results it can be inferred that the prepared sol gel F3 can be best stored at 4 ± 10C.
Table 8: It shows the effect of storage on pH, Gelation temperature, Drug content, Viscosity and Syringeability at 40 ±10 C and room temperature
| Parameter | Initial value | 30 days | 60 days | 90 days | |||
| 40 ±10 C | 250±10C | 40 ±10 C | 250±1C | 40 ±10C | 250±10C | ||
| pH | 7.0 | 7.1 | 7.1 | 7.1 | 7.2 | 7.1 | 7.3 |
| Gelation temperature | 360 C | 360 C | 35.80 C | 360 C | 35.60 C | 360 C | 340 C |
| Drug content | 99.85% | 99.05% | 98.25% | 98.85% | 97.86% | 98.17% | 96.98% |
| Viscosity | 620 cps | 622 cps | 652 cps | 625 cps | 665 cps | 634cps | 679cps |
| Syringeability | Pass | Pass | Pass | Pass | Pass | Pass | Pass |
CONCLUSION
Thermoreversible sol gels are shear thinning systems which show temperature dependent gelation. Cefuroxime axetil a broad spectrum, second generation cephalosporin antibiotic was formulated in to a thermoreversible sol gel formulation for treatment of periodontitis. A combination of Pluronic F127 and Pluronic F108 was used to prepare the gel base.
The FTIR studies revealed the presence of compatibility between the drug and the formulation excipients. PF127 (18%w/v) and PF108 (6%w/v) in combination were selected as the optimized polymer concentration.
The rheological studies confirmed the sol to gel transition at body temperature.
In-vitro drug release study indicated controlled drug release over a period of 7 days.
Formulation F3 containing 18%w/v PF127 and 6%w/v PF108 was the optimized one as it showed gelation near body temperature and 97.84% drug release at the end of 7 days.
The optimized formulation exhibited promising antimicrobial activity against the clinical isolates of P.gingivalis, S.mutans and E.faecalis.
The formulation can be used as once a week application in the treatment of periodontitis.
The future prospects include improving the water solubility of drug, clinical studies, IVIVC studies and long term stability studies.
CONFLICT OF INTERESTS
Declared None
REFERENCES